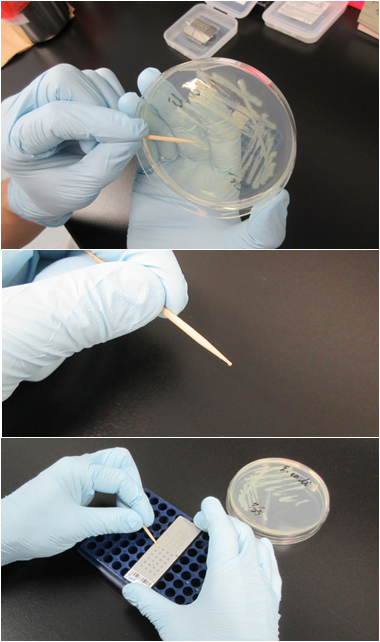
顕微鏡観察

NBRCニュース 第52号
◆◇◆ ━━━━━━━━━━━━━━━━━━━━━━━━━━━━━━━━ ◆◇◆
NBRCニュース No. 52(2018.8.1)
◆◇◆ ━━━━━━━━━━━━━━━━━━━━━━━━━━━━━━━━ ◆◇◆
NBRCニュース第52号をお届けします。夏休みには、いろいろな団体や企業がお子様向け
のイベントを開催しています。7月22日に開催したNITEフレンドシップデイには、多くの
方にお越しいたき、誠にありがとうございました。8月1日、2日には経済産業省で子供
デーが開催されます。NITEも「標準ってなんだろう?~くらしのなかのJISと計量~」の
ブースに参加します。紙パーツを組み立てて作った猫型ノギスを使った長さの測定や、大
人と子どもの聞こえ方の違いを体験できます。ご興味とお時間がある方はぜひご参加くだ
さい。
今号は、前号に引き続き、細菌・アーキアの分類群から見た培養方法の選び方と前々号
に引き続き、定期連載のバイテク分析法としてMALDI-TOF MSを用いた微生物迅速同定法の
続編の2本の連載も掲載しています。最後までお読みいただければ幸いです。
================================================================================
内容
================================================================================
1.新たにご利用可能となった微生物株
2.細菌・アーキアの分類群から見た培養方法の選び方(1)
グラム陽性・低GC細菌(Firmicutes門)後編
~大別した3グループ内における条件分け~
3.バイテク分析法(7)
MALDI-TOF MSを用いた微生物迅速同定法(その2)~実践編~
4.MALDI-TOF MS微生物迅速同定用ライブラリー追加公開のご案内
(2018年8月下旬予定 Acinetobacter属を追加)
5.お盆期間中のNBRC株・DNAリソースの発送休止について
6.NITEバイオテクノロジーセンター展示のお知らせ
================================================================================
1.新たにご利用可能となった微生物株
================================================================================
◆ NBRC株、ゲノムDNA
酵母 2株、糸状菌 40株、細菌 33株が新たにご利用可能となりました。
酵母では、強酸性環境の群馬県の草津白根山源流の河川や秋田県の田沢湖から分離され
た、酸を中和する酵母Candida fluviatilis NBRC 113278及びCryptococcus sp. NBRC
113279を公開しました。
細菌では、培養が比較的難しく、全貌がまだよくわかっていないVerrucomicrobia門に
属する海由来Haloferula属4種5株を公開しました。また、インド洋海底(水深1,675m)か
ら分離されたVirgibacillus indicus NBRC 113014及びVirgibacillus profundi NBRC
113015を公開しました。
【詳細】 https://www.nite.go.jp/nbrc/cultures/nbrc/new_strain/new_dna.html
================================================================================
2.細菌・アーキアの分類群から見た培養方法の選び方(1)
グラム陽性・低GC細菌(Firmicutes門)後編
~大別した3グループ内における条件分け~ (宮下美香)
================================================================================
前号で、NBRCで保存しているFirmicutes門に含まれる代表的な菌種を、気相条件から大
きく3つのグループに分けました。今号ではそれぞれのグループ内における、気相条件以
外の培養条件について紹介します。
◆Bacillales目
NBRC株でこの目に含まれる属種の多くは中温・中性域を好みます。しかし中には、温度
や培地(pH)に特徴のある属種があります。例えばGeobacillus属は高温性(50~70℃)
で、中温域では生育が非常に弱いため高温で培養します。Alicyclobacillus属は高温に加
えて好酸性であり(40~60℃、pH3.0~4.5程度)、高温培養と同時に酸性培地を使用しま
す(参考:NBRCニュース第10号「微生物の培養法(5)」Alicyclobacillus属細菌)。一
方でAlkalibacillus属やHalobacillus属などは中温域を好みますが、学名が表すように
(Alkali-はアルカリ性、Halo-は塩の意味)それぞれ好アルカリ性または好塩性のため、
アルカリ性または塩を含む培地を用います。このように学名の語源も情報になりますが、
培養温度や培地のpH、塩濃度は、NBRCで株ごとに指定している温度や、指定培地の組成や
pHが参考になります。ただし、中性で中温~高温域を好む菌株で、NBRCの802培地やTSA
(Trypticase soy agar)/TSB(Trypticase soy broth)培地、SCD(Soybean Casein Di-
gest)培地が指定されている場合は、指定培地の他に普通寒天培地やLB(Luria-Bertani)
培地といった好気性細菌用の一般的な培地でも生育が可能です。
好酸性や好アルカリ性の場合は適切なpHに調整した培地を用います。NBRCの指定培地で
は調製後に適したpHとなるように設定していますが、高酸性・高アルカリ性条件下で加熱
すると培地成分が壊れる恐れがあることやオートクレーブの前後でpHが変化するなどの理
由から、糖類など分解の恐れがある成分を含む中性付近に調整した液と、無機塩類を含む
高酸性または高アルカリ性に調整した液を別々に用意し、オートクレーブ滅菌した後に混
合するなど、培地調製手順に注意が必要です。
◆Lactobacillales目
乳酸菌は栄養要求性が複雑で富栄養な環境を好むため、Bacillales目細菌のように代替
可能な培地の種類は多くありません。NBRCで乳酸菌の培養に用いる主要な培地はMRS培地
(310培地)、TSYE培地(814培地)、血液や血清を含む培地(347、848培地)です。MRS
培地は乳酸菌の大多数が生育可能ですが、一部の乳酸球菌では、TSYE培地の方が適してい
る場合があります。また、特にヒトや動物を生息域とする菌種には、血液寒天培地でない
と生育が非常に弱い株があります。
乳酸菌の大部分は中温(やや体温寄り)・弱酸性域を好み、糖源としてグルコースを好
みます。例外として、Tetragenococcus属やMarinilactibacillus属のような好塩・好アル
カリ性や、Fructobacillus属やLactobacillus属の一部の種のようにグルコースよりもフ
ルクトースやラクトースなどを好む菌種、アルコール耐性(または要求性)を示す菌種が
存在します。また中にはトマトジュースや乳清などの添加で増殖が著しく向上する菌株も
あります。これらの乳酸菌には、pHや塩濃度、糖源などを変更・追加した培地を用いま
す。指定培地が、一般的な乳酸菌が好む弱酸性で糖源がグルコースという条件から何らか
の変更が加えられている場合は、その条件こそが培養条件設定のポイントと言えます。
◆Clostridiales目
栄養に富んだ培地で旺盛に増殖し、通性嫌気的な扱いでも培養可能な菌種の場合、培地
にはクロストリジア強化培地(902培地)やチオグリコレート培地(807培地)が指定され
ていますが、どちらも使用可能で、これらの培地は市販品もあります。これら以外の指定
培地は、エネルギー源やビタミン類、微量元素、還元剤など多様な要素が影響しあうた
め、指定培地をそのまま用いるのが確実です(参考:NBRCニュース第2号「微生物の培養
法(1)」嫌気性菌の培地調製法)。
================================================================================
3.バイテク分析法(7)
MALDI-TOF MSを用いた微生物迅速同定法(その2)~実践編~ (川崎浩子)
================================================================================
前々回に引き続き、MALDI-TOF MS(MALDI)を用いた微生物迅速同定法について、NBRC
で実施している方法を例に解説いたします。MALDIによる微生物の迅速同定は、(1)前処
理、(2)マトリクス剤との混合、(3)MALDIによるマススペクトルの取得、(4)微生物
同定用マススペクトル・ライブラリーとの照合(指紋判定)、の4つのステップからなり
ます。
(1)前処理
微生物細胞のタンパク質をイオン化させるために細胞を調製するステップのことです。
大腸菌のように比較的容易に細胞が壊れる場合は、前処理の必要はなく、爪楊枝などを用
いてコロニーをわずかに掻き取り(爪楊枝の先に細胞が付いていることが見える程度)、
MALDIのターゲットプレートに直接塗抹するだけです。枯草菌、放線菌、酵母菌、糸状菌
のように比較的細胞が壊れにくい場合は、平板もしくは液体培養した細胞をチューブ内で
ギ酸処理を行い、上清をターゲットプレートに滴下します。NBRCでは、放線菌や糸状菌に
ついて前処理を検討したところ、ビーズによる物理的破砕の有無で結果に差が見られな
かったことから、チューブ内ギ酸処理法を採用しています。糸状菌では、培養方法やコロ
ニーの掻き取り箇所によって細胞形態が異なり、MALDIの結果に影響することが課題で
す。NBRCでは、平板培養(約7日)したコロニーの半分を、滅菌水で湿らせた綿棒を用い
て拭き取り、滅菌水に懸濁した液を解析に使用しています。なお、使用するプラスチック
チューブやチップによっては、ギ酸やアセトニトリルに反応し、正しくデータを取得でき
ない場合がありますのでご注意ください。

図:微生物細胞をターゲットプレートに直接塗抹する様子

図:MALDI-TOF MS微生物同定解析のための糸状菌細胞の調製
(2)マトリクス剤との混合
タンパク質をイオン化させるために行います。細胞を直接塗抹した場合は、塗末部分を
自然乾燥した後、直接マトリクス剤を滴下して測定する方法と、マトリクス剤を滴下する
前にギ酸を滴下してターゲットプレート上で溶菌させてから、マトリクス剤を滴下する方
法の二通りがあります。ギ酸処理を行うことでマススペクトルが検出しやすくなる場合が
あります。一方、前処理においてチューブ内でギ酸処理を行った場合は、上清をターゲッ
トプレートに滴下して自然乾燥させた後、マトリクス剤を滴下して測定します。
(3)MALDIによるマススペクトルの取得
MALDIにターゲットプレートを装着し、レーザーを照射することによってマススペクト
ルを取得します。注意する点として、MALDIの検出感度の高さから、微生物由来のタンパ
ク質以外の物が検出される場合があり、それらも含めて自動的に(4)の指紋判定解析が
行われてしまい、結果として間違った判定をしてしまうことがあります。NBRCでは、取得
ピーク数(70ピーク以上、250ピーク以下)、十分なイオン強度(Microflexの場合
Intensity 1,000程度以上、AXIMAの場合15mV程度以上)、均等なピークバランス(極端に
一つのピークが高い場合は十分なマススペクトルが取得できていない場合がある)、フ
ラットなベースラインを目安として、データ精度を確認しています。
なお、(3)の前にマス値の補正用(キャリブレーション用)の大腸菌サンプルを準備
しておく必要があります。メーカーからキャリブレーション用標準試料が販売されていま
すが、Escherichia coli NBRC 3301を使って調製することもできます。サンプルと同様の
操作により取得したマススペクトルを用いて、キャリブレーションを行います。
(4)微生物同定用マススペクトル・ライブラリーとの照合(指紋判定)
あらかじめ既知種、既知株のマススペクトルデータをライブラリー化したものに対し、
調べたい微生物株のマススペクトルを照合し、その類似性を計算し、微生物を同定しま
す。システム化されたものとして、MALDI Biotyper®とVITEK® MS SARAMIS™が市
販されています。それぞれライブラリーの作り方に違いがあり、結果的に照合方法も異な
ります。MALDI Biotyperのライブラリーは、株毎に作成されており、一株に対しイオン強
度が高い方から約70ピークのマススペクトルを使って作られています。未知株を照合した
場合、同一のマススペクトルがどの程度存在するかによって算出されたスコア値(0.000
~3.000)で評価します。スコア値2.300以上でほぼ確実な種、2.000~2.299で同種もしく
は同属の近縁種という目安になっています。単純計算をすると、照合に用いた70ピーク中
約70%が同じマス値であれば同種の可能性が高いといえます。一方、SARAMISライブラ
リーは、(基本的に)種毎に作成されており、SuperSectraという独自の概念を採用して
います。同一種の複数株のマススペクトルの中で、共通したマススペクトル(基本的に約
35~49ピークで、最低でも20ピーク以上)により構築されています。未知株を照合した場
合、SuperSectraに用いられたマススペクトルの有無を計算して信頼度(%)として評価し
ます。信頼度99.9%で種名が確定、90%以上であれば同一種、80.0%~90.0%であれば近縁種
という目安です。残念ながら、市販の照合用ライブラリーだけでは同定できない微生物種
もあることから、NBRCでは、正しく同定されたNBRC株を用いて微生物同定用マススペクト
ル・ライブラリーを構築し頒布しています。今後もライブラリーの追加及び更新を予定
しておりますので是非ご利用ください。
今回紹介したMALDI微生物迅速同定のNITEプロトコールとライブラリーに関する情報
は、以下より入手できます。
【URL】 https://www.nite.go.jp/nbrc/industry/maldi/maldi.html
================================================================================
4.MALDI-TOF MS微生物迅速同定用ライブラリー追加公開のご案内
(2018年8月下旬予定 Acinetobacter属を追加)
================================================================================
微生物の安全かつ適切な産業利用を支援するために、独自に開発した微生物迅速同定用
のMALDI-TOF MSマススペクトル・ライブラリーを公開しています。今回、新たにAcineto-
bacter属について、ブルカー社製MALDI Biotyper(R)用マススペクトル・ライブラリーと
ビオメリュー社&島津製作所社製SARAMIS(TM)用のSuperSpectraライブラリーを作成し、
2018年8月下旬に公開する予定です。追加公開するライブラリーは、以下より無料で入手
いただけます。
【URL】 https://www.nite.go.jp/nbrc/industry/maldi/maldi.html
================================================================================
5.お盆期間中のNBRC株・DNAリソースの発送休止について
================================================================================
NBRCでは下記の期間中、NBRC株・DNAリソースの発送を休止させていただきます。
発送休止期間:2018年8月8日(水)~15日(水)
発送予定:
7月31日(火)午後~8月3日(金)午前まで受付分 → 8月7日(火)発送
8月3日(金)午後~14日(火)まで受付分 → 8月16日(木)発送
8月15日(水)~16日(木)午前まで受付分 → 8月20日(月)以降順次発送
※分譲受付が集中する場合や分譲標品の形態により、上記の発送日以降になることがご
ざいます。
【詳細】 https://www.nite.go.jp/nbrc/cultures/information/holiday_2018.html
================================================================================
6.NITEバイオテクノロジーセンター展示のお知らせ
================================================================================
以下に出展いたします。ブースではお立ち寄りいただいた皆様からのご相談やご質問に
もお答えします。是非お越しください。
第70回 日本生物工学会大会 附設展示会
日時:2018年9月5日(水)~7日(金)
場所:関西大学 千里山キャンパス
https://www.sbj.or.jp/2018/
ブースでは、ヒト由来微生物やマイクロバイオーム計測レファレンスの提供、微生物を
用いた創薬支援の取り組み、MALDI-TOF MSを用いた微生物の迅速同定法について紹介致し
ます。また、一般講演では、スマートセルインダストリー支援やヒト腸内細菌の網羅的な
分離方法の検討について、NBRCスタッフが口頭発表を行います。
第33回 日本放線菌学会大会
日時:2018年9月11日(火)~12日(水)
場所:武蔵野大学有明キャンパス
https://www.musashino-u.ac.jp/yakugaku/shoyakukagaku/saj33/
この度NBRCでは、菌株の利用環境整備のため、寄託・分譲制度を改正しました。新しい
制度の内容やNBRCの業務内容を紹介します。
================================================================================
編集後記
================================================================================
今更ながら、某公共放送の地形歴史散歩バラエティー番組にハマっています。主に地形
からその土地の暮らしや文化を紐解く番組なのですが、その成り立ちには緻密な必然性が
あり毎回感動します。一方で、実際に行ったことのある場所について紹介されると、そう
いう見方があったのか、と再度訪れたくなる衝動に駆られます。私が京都の宇治を訪れた
ちょうど数日後にその場所について紹介された時は、行くのがもう少し遅ければなと思い
つつ、おぼろげな記憶を手繰り寄せ、宇治土産の煎茶を味わうのでした。ちなみに、幕間
に出てくるパラパラマンガも必見です。(TA)
◆◇◆ ━━━━━━━━━━━━━━━━━━━━━━━━━━━━━━━━ ◆◇◆
・画像付きのバックナンバーを以下のサイトに掲載しております。受信アドレス変更、
受信停止も以下のサイトからお手続きいただけます。
https://www.nite.go.jp/nbrc/cultures/others/nbrcnews/nbrcnews.html
・NBRCニュースは配信登録いただいたメールアドレスにお送りしております。
万が一間違えて配信されておりましたら、お手数ですが、下記のアドレスにご連絡
ください。
・ご質問、転載のご要望など、NBRCニュースについてのお問い合わせは、下記のアド
レスにご連絡ください。
・掲載内容は予告なく変更することがございます。掲載内容を許可なく複製・転載さ
れることを禁止します。
・偶数月の1日(休日の場合はその前後)に配信します。第53号は2018年10月1日に配信
予定です。
編集・発行
独立行政法人製品評価技術基盤機構(NITE)バイオテクノロジーセンター
NBRCニュース編集局(nbrcnews@nite.go.jp)
◆◇◆ ━━━━━━━━━━━━━━━━━━━━━━━━━━━━━━━━ ◆◇◆
お問い合わせ
-
独立行政法人製品評価技術基盤機構 バイオテクノロジーセンター
生物資源利用促進課
(お問い合わせはできる限りお問い合わせフォームにてお願いします)
-
TEL:0438-20-5763
住所:〒292-0818 千葉県木更津市かずさ鎌足2-5-8 地図
お問い合わせフォームへ